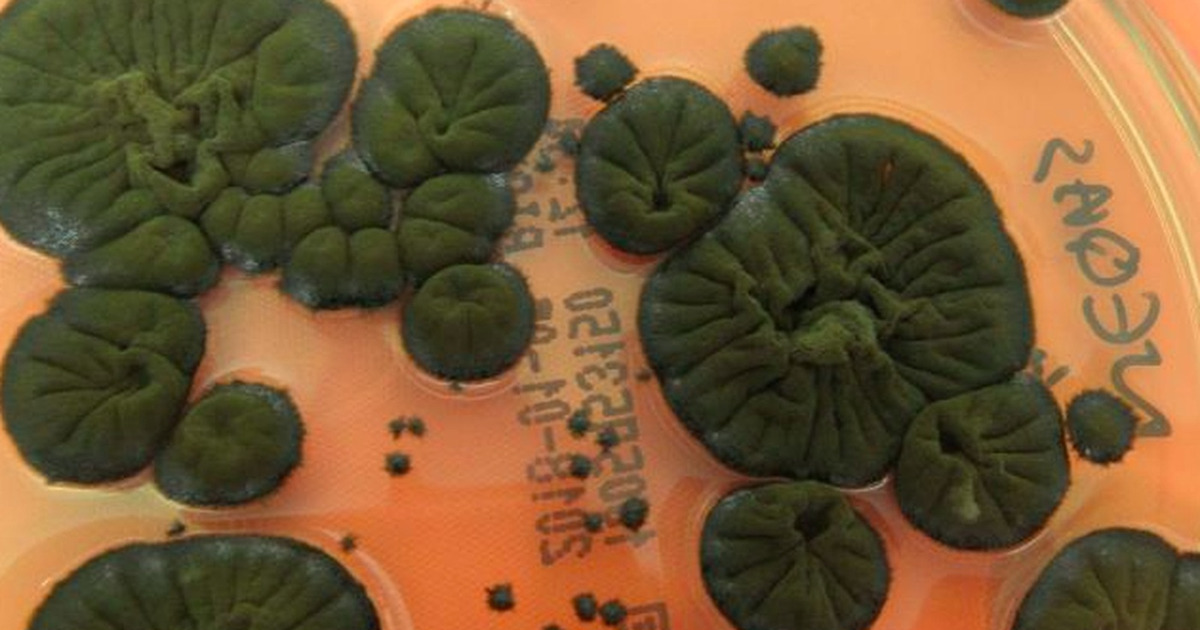
Jamur Super Chernobyl Mengubah Radiasi Jadi Energi

Spilltekno – Di tengah puing-puing bencana nuklir Chernobyl, sebuah fenomena mengejutkan ilmuwan. Sebuah jenis jamur hitam ternyata tidak hanya bertahan, tetapi diduga justru memanfaatkan radiasi ekstrem. Kemampuan unik ini membuat para peneliti tercengang dan menguak misteri baru.
Spesies jamur bernama Cladosporium sphaerospermum ini ditemukan tumbuh subur. Mereka hidup di area dengan tingkat radiasi sangat tinggi, bahkan di dalam reaktor yang hancur pada tahun 1986. Keberadaan mereka di lingkungan mematikan itu sungguh luar biasa.
Penelitian mendalam menunjukkan bahwa organisme ini memiliki pigmen melanin. Melanin tersebut berperan vital dalam proses adaptasi yang menakjubkan ini. Pigmen ini diduga mampu menyerap radiasi ionisasi berbahaya yang merusak sel.
Radiasi ionisasi, yang biasanya memecah molekul dan menyebabkan kerusakan genetik, justru diubah. Jamur ini tampaknya mampu mengubah radiasi tersebut menjadi bentuk energi yang dapat mereka gunakan untuk tumbuh. Proses ini mirip dengan fotosintesis pada tumbuhan, namun dengan sumber energi yang sangat berbeda.
Penemuan ini membuka pemahaman baru tentang batas ketahanan makhluk hidup. Ilmuwan kini tengah mempelajari lebih lanjut mekanisme kerja melanin jamur ini. Potensi aplikasinya di masa depan sangatlah menarik untuk dieksplorasi.
Para peneliti membayangkan penggunaan jamur ini untuk berbagai tujuan inovatif. Misalnya, mereka bisa dimanfaatkan sebagai perisai radiasi alami atau dalam bioremediasi lokasi terkontaminasi. Bahkan, ada spekulasi tentang potensi menghasilkan energi dari limbah radioaktif.
Kemampuan super jamur Chernobyl ini menunjukkan adaptasi luar biasa di alam semesta. Ini membuktikan bahwa kehidupan dapat menemukan cara untuk bertahan dalam kondisi paling ekstrem sekalipun. Kisah jamur ini adalah pengingat akan keajaiban dan misteri di sekitar kita.
Penelitian terus berlanjut untuk memahami sepenuhnya fenomena unik ini. Penemuan ini bisa mengubah cara kita memandang radiasi dan energi. Dunia sains selalu penuh kejutan yang menunggu untuk diungkap.
Ikuti terus berita teknologi lainnya hanya di Spilltekno